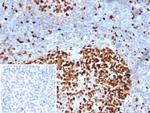
MCM3 (Proliferation Marker) Antibody in Immunohistochemistry (Paraffin) (IHC (P))

Search
NeoBiotechnologies
MCM3 (Proliferation Marker) Monoclonal Antibody (MCM3/6706)
{{$productOrderCtrl.translations['antibody.pdp.commerceCard.promotion.promotions']}}
{{$productOrderCtrl.translations['antibody.pdp.commerceCard.promotion.viewpromo']}}
{{$productOrderCtrl.translations['antibody.pdp.commerceCard.promotion.promocode']}}: {{promo.promoCode}} {{promo.promoTitle}} {{promo.promoDescription}}. {{$productOrderCtrl.translations['antibody.pdp.commerceCard.promotion.learnmore']}}
产品信息
4172-MSM4-P1
种属反应
宿主/亚型
分类
类型
克隆号
抗原
偶联物
形式
浓度
规格
纯化类型
保存液
内含物
保存条件
运输条件
产品详细信息
Positive Control: Jurkat or Ramos cells. Human colon or tonsil. MCF-7
Cellular Location: Nucleus.
靶标信息
The protein encoded by this gene is one of the highly conserved mini-chromosome maintenance proteins (MCM) that are involved in the initiation of eukaryotic genome replication. The hexameric protein complex formed by MCM proteins is a key component of the pre-replication complex (pre_RC) and may be involved in the formation of replication forks and in the recruitment of other DNA replication related proteins. This protein is a subunit of the protein complex that consists of MCM2-7. It has been shown to interact directly with MCM5/CDC46. This protein also interacts with, and thus is acetlyated by MCM3AP, a chromatin-associated acetyltransferase. The acetylation of this protein inhibits the initiation of DNA replication and cell cycle progression.
仅用于科研。不用于诊断过程。未经明确授权不得转售。
篇参考文献 (0)
生物信息学
蛋白别名: cervical cancer proto-oncogene 5; DNA polymerase alpha holoenzyme-associated protein P1; DNA replication factor MCM3; DNA replication licensing factor MCM3; hRlf beta subunit; MCM3 minichromosome maintenance deficient 3; MGC1157; minichromosome maintenance deficient 3; P1-MCM3; p102; replication licensing factor, beta subunit; RLF subunit beta; RP1-108C2.3; unnamed protein product
基因别名: HCC5; MCM3; P1-MCM3; P1.h; RLFB
UniProt ID: (Human) P25205
Entrez Gene ID: (Human) 4172